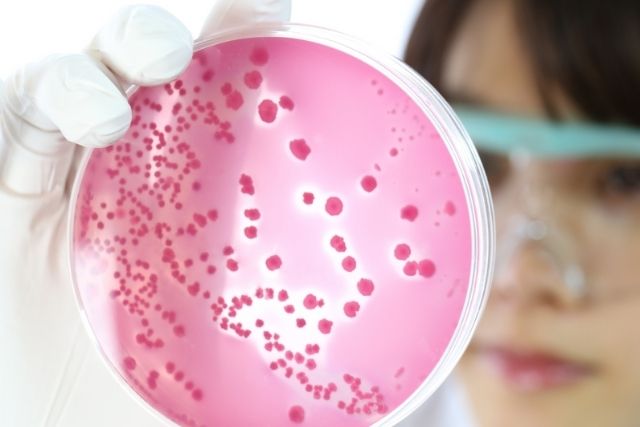
image

Catalan Researchers Unearth Fossilized Chromosomes in 52,000-Year-Old Mammoth
A team of Catalan researchers from the Spanish Genome Analysis Center and the Genomic Regulation Center in Barcelona has made a groundbreaking discovery. They have identified fossilized ancient chromosomes in a 52,000-year-old mammoth found in Siberia. This significant find, published in Cell magazine, preserves the structure of the ancient chromosomes down to the nanometer scale.
Dr. Marcela Sandoval-Velasco of the Center for Evolutionary Hologenomics at the University of Copenhagen, co-first author of the study, remarked, "We’ve known that tiny fragments of ancient DNA can survive for long periods of time. But what we found here is a sample where the three-dimensional arrangement of these DNA fragments was frozen in place for tens of millennia, thereby preserving the structure of the whole chromosome."
A Leap in Understanding Ancient DNA
Traditionally, ancient DNA fragments retrieved from fossils rarely contained more than 100 letters of the genetic code, far smaller than the full DNA sequence of any organism. This discovery allows scientists to study these sequences in much greater detail, spanning hundreds of millions of genetic letters. It also provides insight into which DNA chains were in contact at the time of the mammoth's death, offering a deeper understanding of gene activation and inactivation.
ICREA Research Professor Marc A. Marti-Renom explained, "Fossil chromosomes are a game-changer. Knowing the shape of an organism’s chromosomes makes it possible to assemble the entire DNA sequence of extinct creatures, enabling insights that would not have been possible before."
Detailed Insights and Exciting Revelations
Olga Dudchenko, associate professor at the Center for Theoretical Biological Physics at Rice University, highlighted the significance of the discovery, noting, "We found that they have 28 pairs of chromosomes, which makes a lot of sense, because that’s what modern elephants have, and they are the woolly mammoth’s closest living relative."
Juan Antonio Rodríguez, a researcher at the University of Copenhagen and the Spanish Genome Analysis Center, expressed his excitement, "It was extremely exciting to be able to count the chromosomes of an extinct creature for the first time. It is usually not possible to have this much fun simply counting from one to twenty-eight."
A Physics Mystery Solved
Dudchenko also noted the scientific conundrum posed by the existence of these chromosome fossils. "Einstein’s work makes a very simple prediction about chromosome fossils: under ordinary circumstances, they shouldn’t exist," Dudchenko said before adding, "and yet, here they are. It was a physics mystery!"